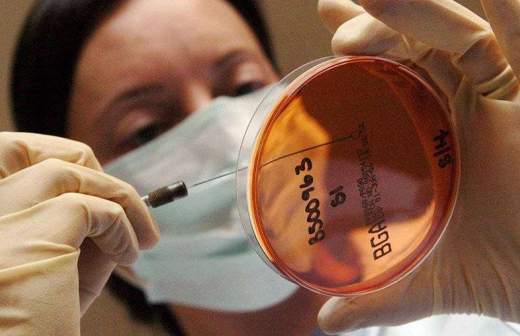

Зараженное сальмонеллой мясо нашли в Хабаровске
Бактерии сальмонеллы обнаружены в мясе, которое могло попасть на прилавки магазинов Хабаровского края. Исследование проводило ФГБУ «Хабаровский референтный центр Федеральной службы по ветеринарному и фитосанитарному надзору». Всего найдено около 4 т опасной буйволятины.
Как сообщает ИА AmurMedia, партия находилась на одном из предприятий по переработке и хранению мясной продукции. Выяснилось, что продукция была привезена из Индии.
Портал iz.ru 7 мая сообщал об отравлении семерых жителей Челябинска после покупки готовых салатов в супермаркете «Лента». В продукции, которую они употребляли, нашли бактерии сальмонеллы.